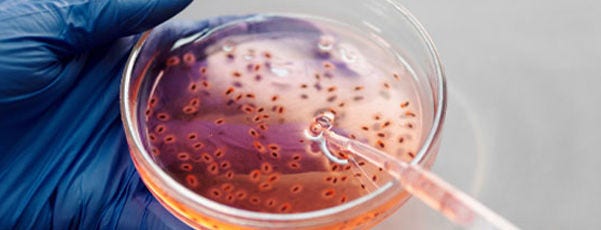
Cell Lines and Cell Culture

Quality Management is a core value at the Fisher Scientific channel and we are committed to providing our customers with superior service and exceeding their expectations. We fulfil our mission to enable our customers to make the world healthier, cleaner and safer by continuously improving the quality of our products and services and by ensuring global regulatory compliance.
Through this commitment we have developed our SureTRACE and SureTRACE+ programs. Both provide full traceability through lot visibility, guaranteed access to associated certificates and a supplier commitment to notify you of changes impacting quality and supply.
SureTRACE is an automated self-serve solution for a specific range of standard catalog products ordered through the Fisher Scientific website – all at no additional cost, whereas, as the name suggests, SureTRACE+ provides you with the next level of service. SureTRACE+ is a value-added service focused on a customized selection of standard catalog products. It additionally includes solutions to strengthen security of supply for your critical products and is expertly managed by our dedicated Production Solutions Team.